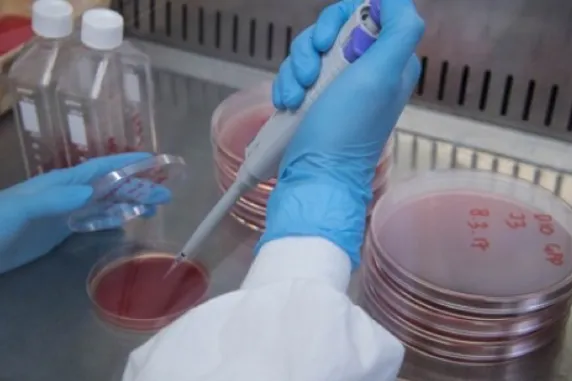
Menzies

The Thrive Lab
The Thrive Lab set up by the College of Indigenous Futures, Education and the Arts is focused on building scientific foundations for developing resilient, adaptable and sustainable communities. It will explore issues such as humanitarian aid, disaster management, community development, governance and policy, and built infrastructure.
THRIVE Lab brings together researchers, practitioners, teachers and students to work collaboratively on contemporary challenges of human-environment relations.
We examine and engage in active research and learning about:
- disaster and emergency management
- climate change impacts and adaptation
- changing geographies of settlement and work
- food security and natural resource management.
To gain fresh insight and develop practical responses to these issues, we draw on:
- transdisciplinary approaches
- action research principles
- work-integrated learning
- collaborative, practitioner-enabling research practices
- student-integration into research and practice.
Our courses provide teaching, training and research in areas central to the THRIVE Lab.
Our Projects to date include:
- Building Resilience in Indigenous Communities through Engagement: A Focus on Biosecurity Threats
- NT Department of Health, Alcohol and Other Drugs Branch - Heat Stress, Alcohol Use and Economic Participation Among Labour-intensive Workers in Tropical Conditions.
- Scoping Study for Department of Defence, Joint Force Analysis, Preparedness and Mobilisation - Implications of heat stress for Australian Defence preparedness and operations under current and future climatic conditions.
- Development of a Heat Stress Management App for the Northern Territory.
- Handbook for Migrants Looking for Work in the Northern Territory, NT Department of Territory Families.
- Global mapping of political will – Measuring countries commitment to disaster risk reduction and climate adaptation.
- Social network and disaster research
- Urban climate adaptation in Indonesia.
- Community-based disaster risk reduction.
- Disaster governance in Southeast Asia.
- Food systems under changing the climate.
- Longitudinal observation of child-centred climate change adaptation and disaster risk reduction in Indonesia
- How post-disaster need assessment inform recovery planning and policy in Pacific
- Long term observation of disaster recovery in the Asia Pacific
- Use of Remotely Piloted Air System (RPAS) or drones for risk assessment and disaster response
- Climate change impacts on agriculture and livestock
Menzies School of Health Research
For over 30 years, the Menzies School of Health Researchhas been a beacon for scientific discovery and public health achievements. Menzies aims to create sustainable health improvements through translatable research with direct impact. As one of Australia’s leading medical research institutes dedicated to improving the health and wellbeing of Indigenous Australians, and a leader in global and tropical research into life-threatening illnesses, Menzies continues to translate its research into effective partnerships and programs in communities across Australia and the Asia-Pacific region.
Work undertaken by Menzies addresses critical issues such as mental health, nutrition, substance abuse, child health and development, as well as chronic diseases including cancer, kidney disease and heart disease. Menzies also leads global research into life-threatening illnesses in the Asia-Pacific, such as malaria, melioidosis and tuberculosis. Menzies endeavours to break the cycle of disease and to reduce health inequities in Australia and the Asia-Pacific region, particularly for disadvantaged populations.
Menzies’ mandate is to seek enduring solutions to problems that matter and to achieve sustainable health improvements through excellence and leadership in research, education and capacity development.
Focus on social and cultural sustainability in developing the North
Jane Munday, a PhD candidate at the Northern Institute of Charles Darwin University has been researching models of cultural and social impact assessment that will deliver sustainable social, cultural, ecological and economic development of the North, paying particular attention to more participatory processes. Jane’s preliminary findings from her research include an audit of all environmental impact assessments done in the Northern Territory since the Ranger Uranium Mine in 1974. Her research methods have encompassed interviews with regulators, Aboriginal organisations, NGOs, companies, social and environmental practitioners around Australia exploring the evolution of impact assessment. As part of her research, Jane evaluates dimensions of quality impact assessment, interviewees’ perceptions of gaps in current practices and how social and cultural impact assessment can better inform good decision-making.